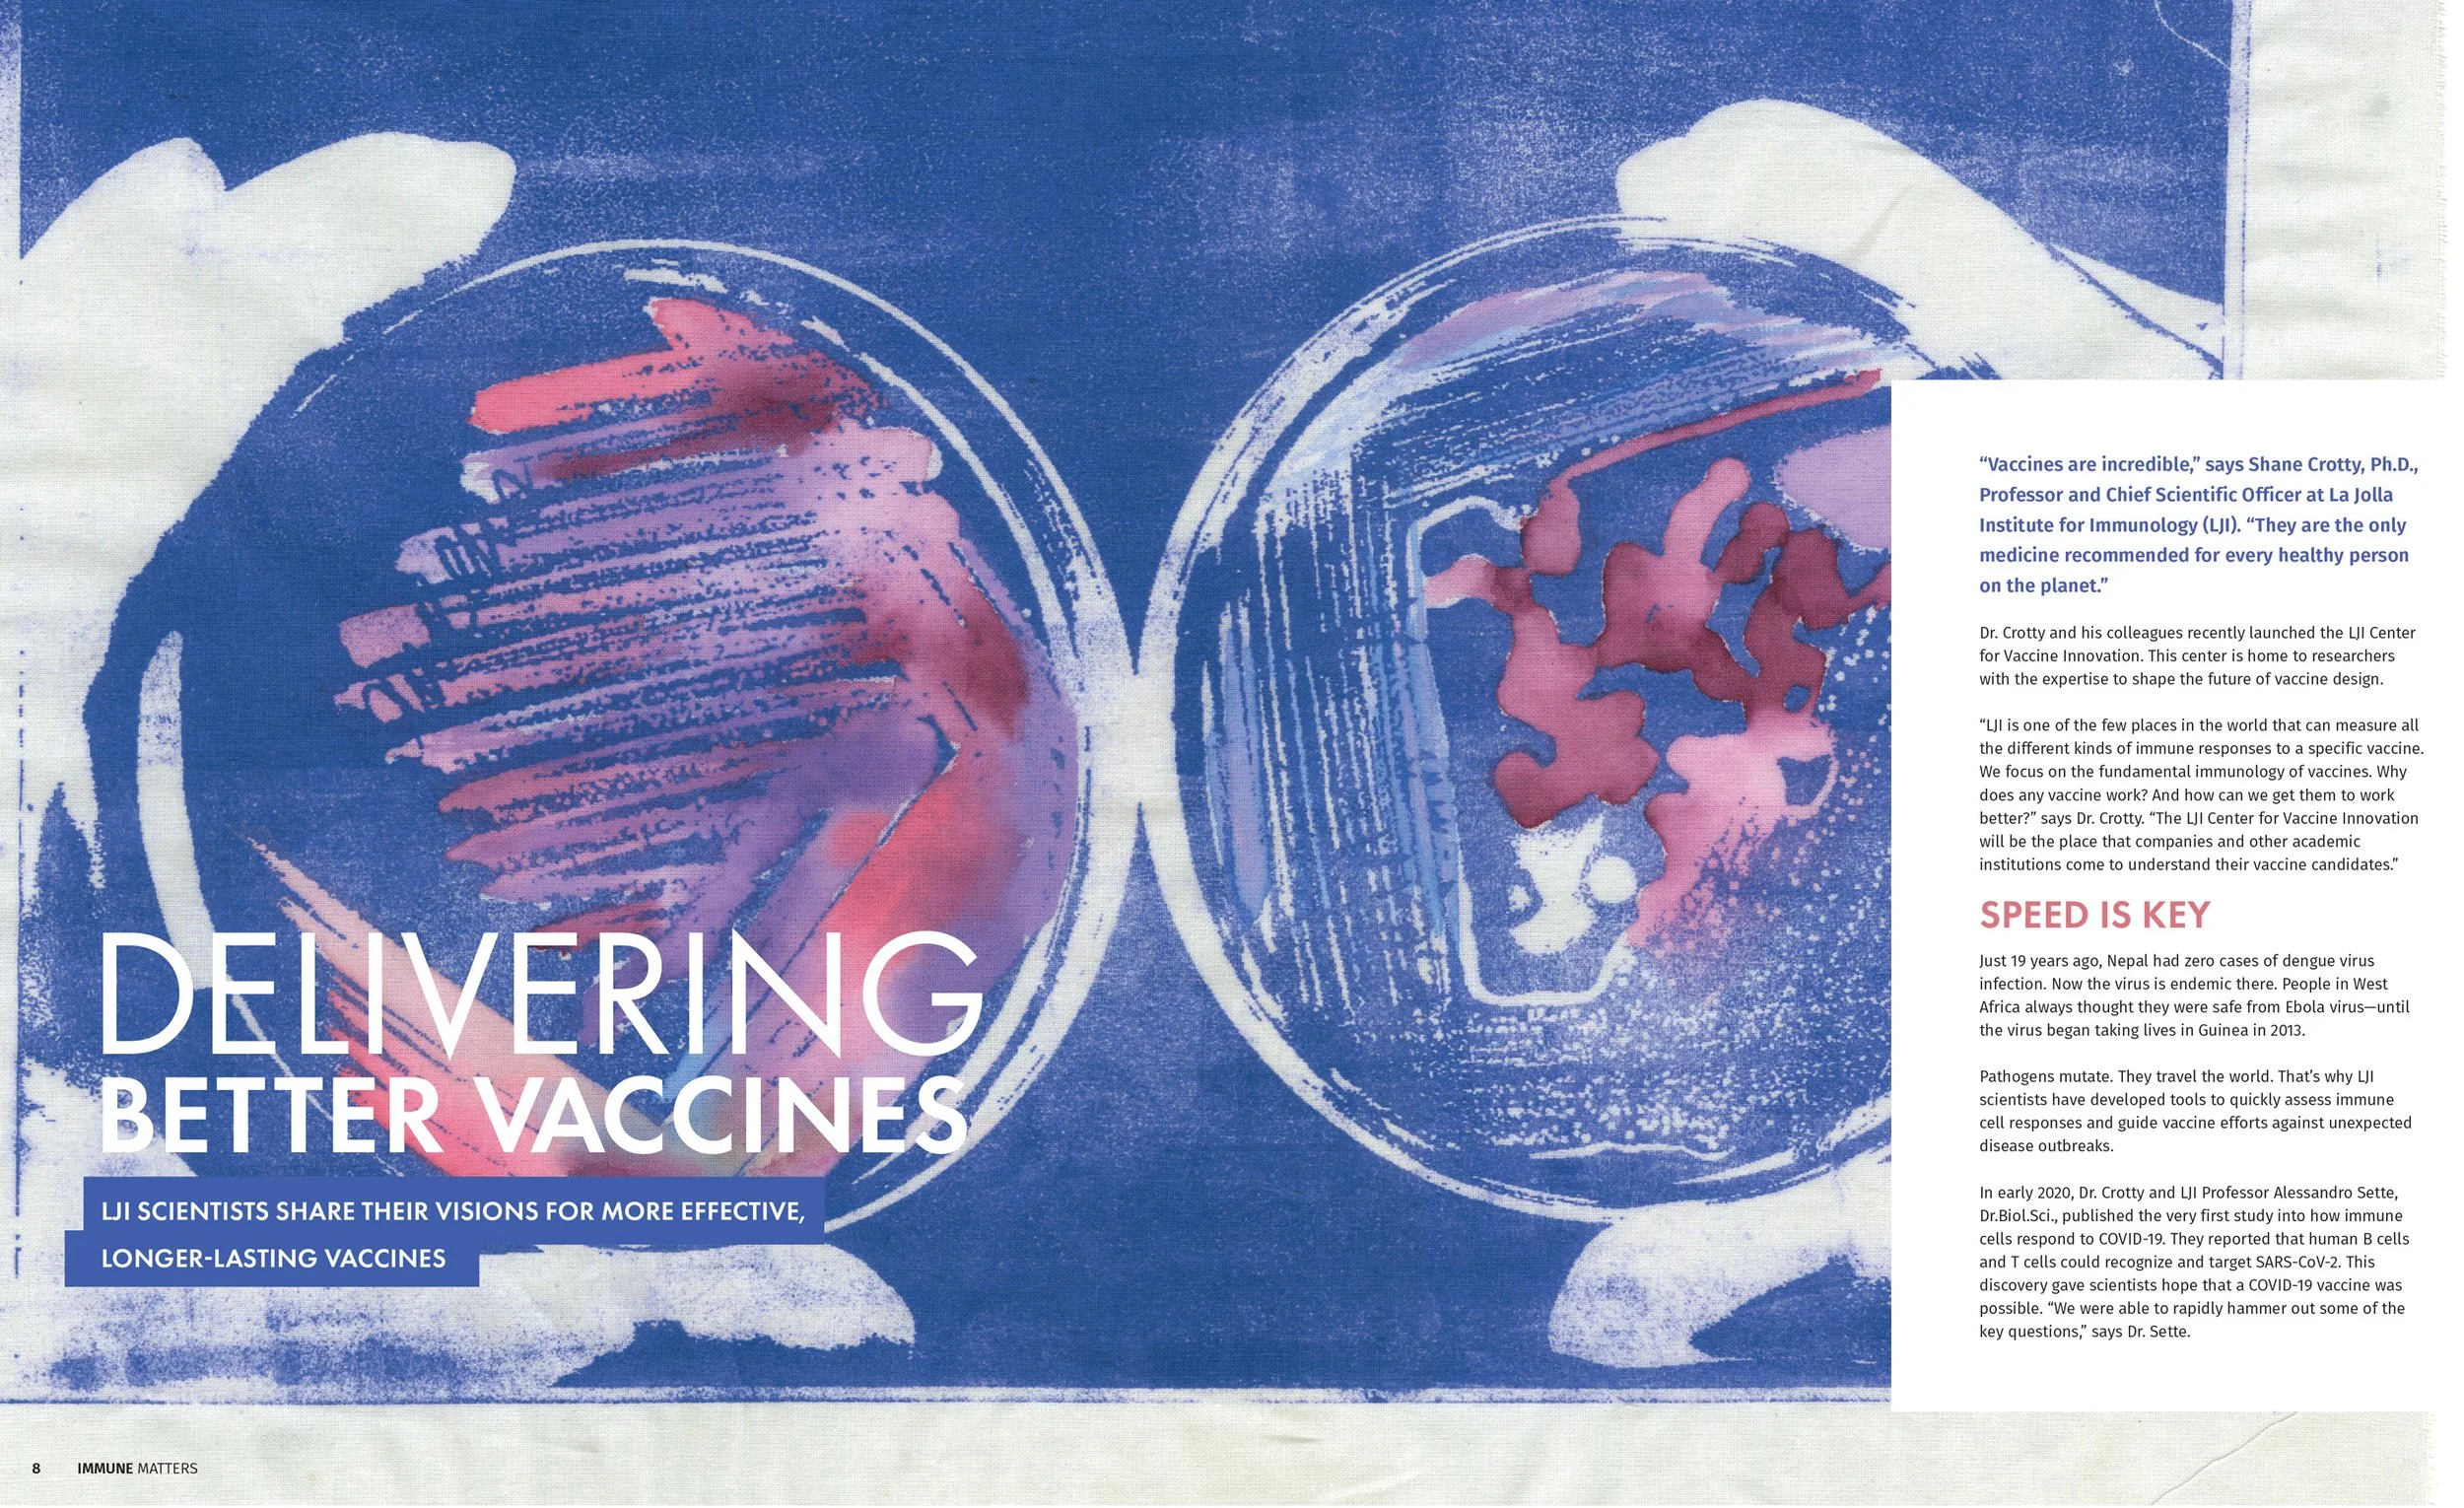

La Jolla Institute for Immunology
Imagine Life Without Disease
La Jolla Institute for Immunology (LJI) solely dedicates itself to understanding the far-reaching power of the immune system, believing that no other biomedical discipline has greater implications than immunology for improving human health.
Immune Matters
Studio L. collaborated with LJI to design their twice-yearly Immune Matters publication. Our goal for each edition was to highlight the Institute’s importance as one of the world’s most influential centers for immunology research. In addition, establish a way to creatively introduce the people that make research happen and emphasize the importance of funding in order to continue research.
Art Direction
Graphic Design
Editorial Design
Conceptualization and Strategy

The Tullie and Rickey Families SPARK Awards for Innovations in Immunology provides flexible start-up funding to early career investigators to act on their promising projects. Studio L. collaborated with LJI to design and brand their SPARK suite of materials, including icon design, layout and design for their annual report, and annual appeal mailer.












Life Without Disease event series postcards and evite layout and branding.

Client
The Atlas Project
Year
01/01/0001
